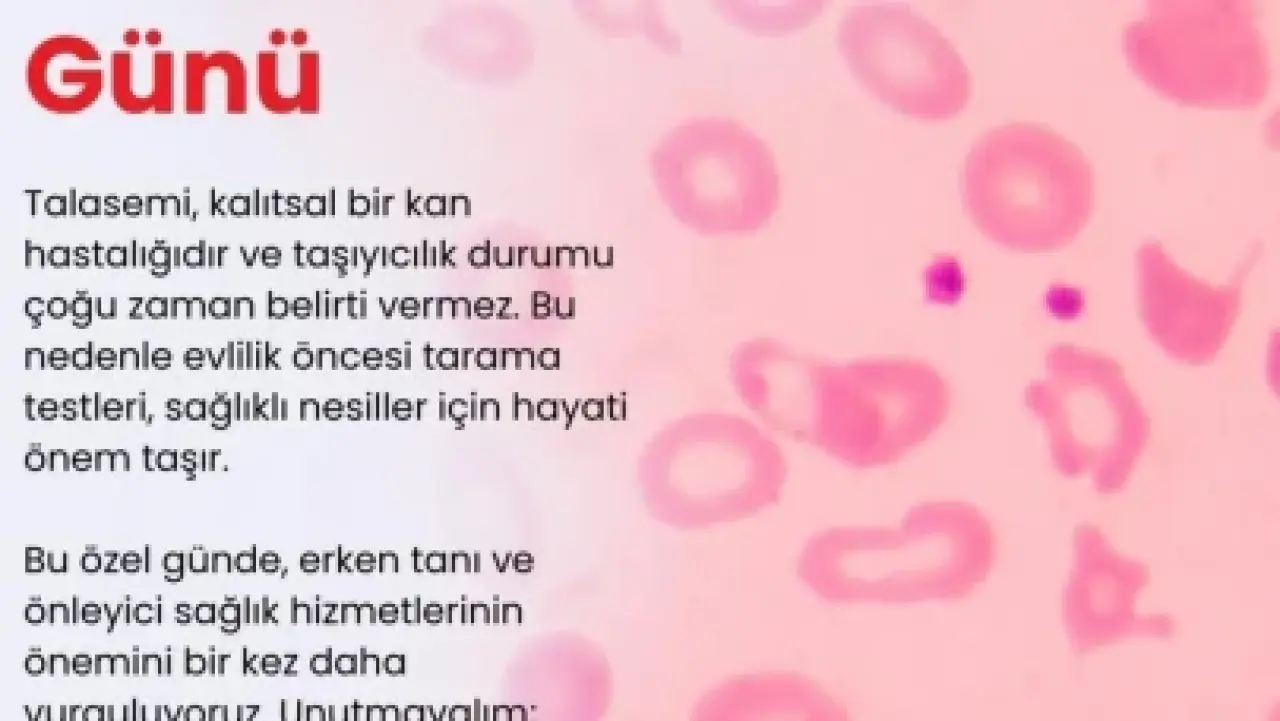

İzmir Ekonomi Üniversitesi Medical Point Hastanesi, obezite cerrahisinde multidisipliner yaklaşımla öncü rol üstleniyor. Uzman cerrahlar, diyetisyenler, psikologlar, endokrinologlar ve hemşirelerden oluşan özel bir ekip, hastalara kişiye özel bütüncül tedavi süreçleri sunarak, obeziteyle mücadelede önemli adımlar atıyor. Bu yaklaşım, hastaların yaşam kalitesini artırmayı ve obeziteye bağlı sağlık risklerini azaltmayı hedefliyor.
Obezite Cerrahisinde Multidisipliner Yaklaşım
Medical Point Hastanesi'ndeki obezite cerrahisi ekibi, Genel Cerrahi Uzmanları Op. Dr. Gülden Ballı ve Op. Dr. Serhat Buldur'un liderliğinde çalışmalarını yürütüyor. Ekip, cerrahi operasyonların yanı sıra, hastaların ameliyat öncesi ve sonrası süreçlerini de titizlikle takip ederek, sağlıklı bir yaşama adım atmalarını destekliyor. Başarılı sonuçlar, ekip çalışmasının ve hasta odaklı yaklaşımın bir sonucu olarak öne çıkıyor.

Kişiye Özel Tedavi Planlaması
Op. Dr. Serhat Buldur, her hastanın ihtiyacının farklı olduğunu vurgulayarak, kişiye özel disiplinler arası bir planlama yapıldığını belirtiyor. Hastane, obezite cerrahisini sadece bir ameliyat olarak değil, aynı zamanda bir yaşam tarzı değişikliği olarak ele alıyor. Bu nedenle, hastalara ameliyat öncesi ve sonrası psikolojik destek, beslenme danışmanlığı ve metabolik takip gibi kapsamlı hizmetler sunuluyor.

Yaşam Kalitesini Artırma Hedefi
Op. Dr. Gülden Ballı, obezite cerrahisinin sadece kilo verdirmekle kalmayıp, bireyin yaşam kalitesini artırma ve kalp-damar hastalıkları ile diyabet gibi riskleri azaltma konusunda önemli bir adım olduğunu ifade ediyor. Hastalara bu bilinçle yaklaşıldığını ve tedavi sürecinin bu doğrultuda şekillendirildiğini belirtiyor. Amaç, hastaların daha sağlıklı ve mutlu bir yaşam sürmelerini sağlamak.
Ameliyat Öncesi ve Sonrası Destek
Medical Point Hastanesi, obezite cerrahisi sürecinde hastalara kapsamlı bir destek sunuyor. Ameliyat öncesi dönemde, hastaların psikolojik olarak hazırlanması ve doğru beslenme alışkanlıkları kazanması hedefleniyor. Ameliyat sonrası dönemde ise, düzenli kontroller ve beslenme danışmanlığı ile hastaların kilo verme süreçlerinin sağlıklı bir şekilde ilerlemesi sağlanıyor. Metabolik takip ile de hastaların genel sağlık durumları yakından izleniyor.
Başarıda Ekip Çalışmasının Önemi
Obezite cerrahisindeki başarının sırrı, uyumlu bir ekip çalışması ve hastalarla kurulan güven ilişkisinde yatıyor. Medical Point Hastanesi'ndeki uzman ekip, her hastanın bireysel ihtiyaçlarını dikkate alarak, en uygun tedavi yöntemini belirliyor. Bu sayede, hastaların obeziteyle mücadelede başarılı sonuçlar elde etmesi ve sağlıklı bir yaşama kavuşması hedefleniyor. Hastane, bu alandaki öncü çalışmalarına devam etmeyi amaçlıyor.